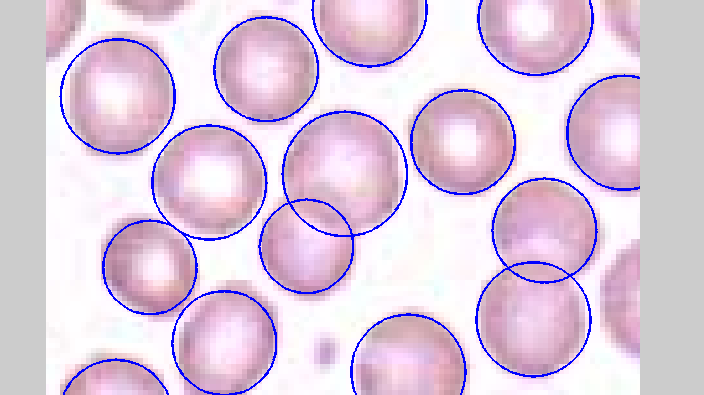

Story Telling Game AI
Multiplayer web application generating random words and using AI-driven story creation to build collaborative narratives between players. Developed with Node.js backend, React frontend, MongoDB database, Redis for real-time communication, and deployed on AWS infrastructure.
-
tags:
- #javaScript
- #typeScript
- #node.js
- #react
- #mongoDB
- #networking
- #ai
- #redis


Gmail Automatic Responder
Chrome extension that automatically generates intelligent email responses using a RAG (Retrieval-Augmented Generation) system with embeddings. Built with Node.js backend, React interface, and MongoDB storage, enabling context-aware automated replies for Gmail users.
-
tags:
- #javaScript
- #typeScript
- #node.js
- #react
- #mongoDB
- #ai
- #machine learning
- #npm


AI Music Detector
Web application for detecting AI-generated music within Spotify libraries. Built using Node.js, React, and MongoDB, designed to analyze and classify audio content to help users identify artificially generated tracks. Includes production-ready deployment and cloud hosting.
-
tags:
- #javaScript
- #node.js
- #react
- #mongoDB
- #ai
- #machine learning
- #big data


Genetic algorithm
A script solving a Knapsack problem with a genetic algorithm.
-
tags:
- #matlab
- #algorithms
- #machine learning


Image processing - edge detection
A script which finds edges on images.
-
tags:
- #matlab
- #algorithms

Image processing - circle detection
A script which finds circles on images.
-
tags:
- #matlab
- #algorithms

